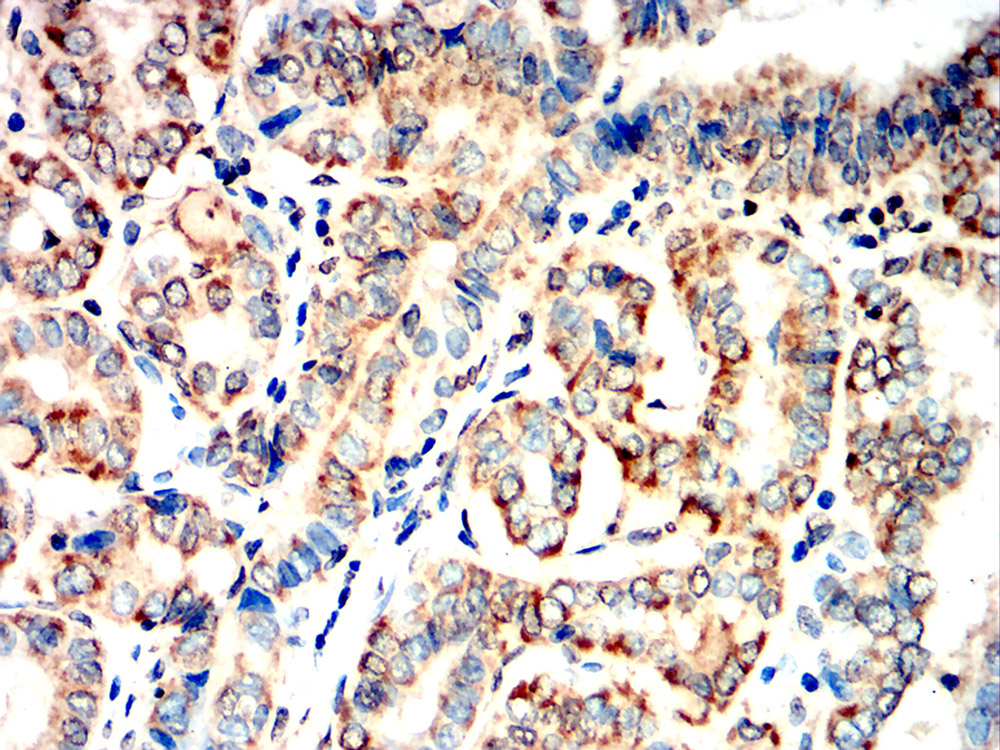
IHC

WB
Western blot analysis using CYP11A1 antibody against Hep G2 (1), Jurkat (2) cell lysate.12% SDS-PAGE gel.Sample loading: 20μg /lane. Transfer the proteins onto a PVDF membrane (
OM790003), and block it with TBST (
OM750016) plus skimmed milk powder for one hour. Dilute the primary antibody with the antibody diluent (
OM750012) at a ratio of 1:1000, and incubate it overnight at 4°C. Wash the membrane three times with TBST (
OM750016), 5 minutes each time. At room temperature, dilute the secondary antibody, Goat Anti-Rabbit IgG(H&L)-HRP (
OM643487), at a ratio of 1:20000 and incubate for one hour. Wash the membrane three times with TBST (
OM750016) again, 5 minutes each time. Use ECL (
OM625701) for luminescence.staining time: 60S.
IHC
Immunohistochemical analysis of paraffin-embedded thyroid carcinoma tissues using CYP11A1 antibody with DAB staining.Pre-treat the sections with heat-mediated antigen retrieval using sodium citrate buffer (pH 6.0) (
OM750020) for 2 minutes. Wash the sections with ddH₂O and PBS (
OM750003). Block the tissue with 10% non-immune goat serum(
OM760028) at room temperature for 30 minutes. Incubate the tissue with the primary antibody diluted at a ratio of 1:1500 at 4°C overnight. At room temperature, dilute the secondary antibody, Goat Anti-Rabbit IgG(H&L)-HRP (
OM643487), at a ratio of 1:200 and incubate for one hour. Use DAB(
OM760029)as the chromogenic agent. Counterstain the tissue with hematoxylin, and mount the tissue sections with neutral gum.
ICC/IF
Immunofluorescence analysis of HepG2 cells using CYP11A1 antibody(green). Blue: DAPI fluorescent DNA dye. Red: Actin filaments have been labeled with Omnimabs® 594-Phalloidin.Cells are fixed in 4% paraformaldehyde at room temperature for 20 minutes. Then, they are permeabilized with a PBS (
OM750003) solution containing 0.1% Triton X-100(
OM750021) at room temperature for 15 minutes. Subsequently, the cells are blocked with 10% non - immune goat serum(
OM760028) at room temperature for 1 hour.The cells are incubated overnight at 4°C with the primary antibody diluted 1:100 in PBS. The secondary antibody, Omnimabs® 488 Goat Ant-Rabbit IgG(H&L) (Green,
OM643486), is diluted at a ratio of 1:400 and incubated with the cells for 1 hour.Nuclear DNA is labeled with DAPI (Blue,
OM643160). F-actin is stained with Omnimabs® 594-Phalloidin (Red,
OM750007) diluted 1:100 for 30 minutes.
IHC
Immunohistochemical analysis of paraffin-embedded renal carcinoma tissues using CYP11A1 antibody with DAB staining.Pre-treat the sections with heat-mediated antigen retrieval using sodium citrate buffer (pH 6.0) (
OM750020) for 2 minutes. Wash the sections with ddH₂O and PBS (
OM750003). Block the tissue with 10% non-immune goat serum(
OM760028) at room temperature for 30 minutes. Incubate the tissue with the primary antibody diluted at a ratio of 1:1500 at 4°C overnight. At room temperature, dilute the secondary antibody, Goat Anti-Rabbit IgG(H&L)-HRP (
OM643487), at a ratio of 1:200 and incubate for one hour. Use DAB(
OM760029)as the chromogenic agent. Counterstain the tissue with hematoxylin, and mount the tissue sections with neutral gum.
WB
Western blot analysis using CYP11A1 antibody against Mouse stomach(1),Rat stomach(2) tissue.
12% SDS-PAGE gel.Sample loading: 20μg /lane. Transfer the proteins onto a PVDF membrane (OM790003), and block it with TBST (OM750016) plus skimmed milk powder for one hour. Dilute the primary antibody with the antibody diluent (OM750012) at a ratio of 1:1000-1:2000, and incubate it overnight at 4°C. Wash the membrane three times with TBST (OM750016), 5 minutes each time. At room temperature, dilute the secondary antibody, Goat Anti-Rabbit IgG(H&L)-HRP (OM643487), at a ratio of 1:20000 and incubate for one hour. Wash the membrane three times with TBST (OM750016) again, 5 minutes each time. Use ECL (OM625701) for luminescence.staining time: 60S.